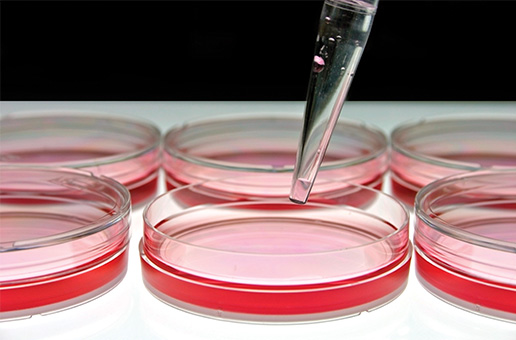

Streszczenie
W salonie kosmetycznym, oprócz narzędzi i rąk personelu, również powierzchnie mogą stanowić źródło zakażeń i zagrożenie dla klientów oraz osób pracujących w zakładzie. Powierzchnie w salonach kosmetycznych i fryzjerskich można użytkowo podzielić na małe (stoliki, fotele) i duże (ściany, podłogi), wrażliwe (skóra, delikatne materiały) i odporne (metale, szkło). Ryzyko wystąpienia zakażeń jest związane z obecnością w środowisku pomieszczenia różnych szczepów wirusów, bakterii oraz grzybów na wszystkich rodzajach powierzchni nieożywionych. W celu zapewnienia odpowiedniego poziomu czystości mikrobiologicznej kreślonych obszarów należy przestrzegać zasad dezynfekcji i w przemyślany sposób dobierać środki dezynfekcyjne, realizując założenia planu higieny opracowane z myślą o konkretnym salonie kosmetycznym lub fryzjerskim.
Słowa kluczowe: powierzchnie, bakterie, wirusy, grzyby, dezynfekcja
Abstract
In beauty salon, in addition to tools and hands of staff, also surfaces can be a source of infection and the risk for customers and people working on site. Surfaces in beauty salons and hairdressers can be usefully divided into small (tables, chairs) and large (walls, floors), sensitive (skin, soft materials) and resistant (metal, glass). The risk of infection is associated with the presence of viruses, bacteria and fungi on the surfaces. In order to ensure adequate level of microbiological cleanness, man should follow the rules of disinfection and thoughtfully select disinfectants due to health plan assumptions introduced in a specific beauty salon or hairdressers.
Key words: surfaces, bacteria, viruses, fungi, disinfection
Agata Jabłońska-Trypuć
MEDILAB, Białystok
Czytaj całość: Kosmetologia Estetyczna, 2 (4), 2013, 293-296